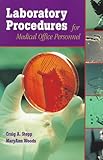
Amazon cover image

Results
|
|
281.
|

Image from Amazon.com
|
Rheumatoid arthritis / by
Edition: 1st ed.
Material type:  Text Text
Publication details: Philadelphia : Mosby/Elsevier, c2009
Availability: Items available for loan: Directorate of Library Services (1)Call number: MED 933.R423.
|
|
|
282.
|

Image from Amazon.com
|
Physical diagnosis of pain : by
Edition: 1st ed.
Material type:  Text Text
Publication details: Philadelphia, PA : W.B. Saunders, 2006
Availability: Items available for loan: Directorate of Library Services (1)Call number: MED RC925.W34.
|
|
|
283.
|

Image from Amazon.com
|
|
|
|
284.
|

Image from Amazon.com
|
Breast pathology / by Series:
Edition: 2nd ed.
Material type:  Text Text
Publication details: Philadelphia, PA : Elsevier/Saunders, c2011
Availability: Items available for loan: Directorate of Library Services (1)Call number: MED RC280.B8B725.
|
|
|
285.
|

Image from Amazon.com
|
Endodontics / by
Edition: 2d ed.
Material type:  Text Text
Publication details: Philadelphia : Lea & Febiger, 1976
Availability: Items available for loan: Directorate of Library Services (1)Call number: MED RK351.I5.
|
|
|
286.
|

Image from Amazon.com
|
|
|
|
287.
|

Image from Amazon.com
|
|
|
|
288.
|

Image from Amazon.com
|
Vaginal surgery for the urologist / by Series:
Material type:  Text Text
Publication details: Philadelphia : Elsevier/Saunders, 2012
Availability: Items available for loan: Directorate of Library Services (3)Call number: MED RG104.V37, ...
|
|
|
289.
|

Image from Amazon.com
|
Kelley's textbook of rheumatology / by
Edition: 9th ed.
Material type:  Text Text
Publication details: Philadelphia, PA : Elsevier/Saunders, [2013]-
Availability: Items available for loan: Directorate of Library Services (1)Call number: MED RC927.F57.
|
|
|
290.
|

Image from Amazon.com
|
Kelley's textbook of rheumatology / by
Edition: 8th ed.
Material type:  Text Text
Publication details: Philadelphia, PA : Saunders/Elsevier, c2009
Availability: Items available for loan: Directorate of Library Services (3)Call number: MED RC927.T49, ...
|
|
|
291.
|

Image from Amazon.com
|
Postpolio syndrome / by
Material type:  Text Text
Publication details: Philadelphia : Hanley & Belfus, c2004
Availability: Items available for loan: Directorate of Library Services (1)Call number: MED RC180.1 .P6733.
|
|
|
292.
|

Image from Amazon.com
|
Diseases of the breast by
Material type:  Text Text
Publication details: Philadelphia : Lippincott-Raven Publishers, 1996
Availability: Items available for loan: Directorate of Library Services (1)Call number: MED RC280.B8D49.
|
|
|
293.
|

Image from Amazon.com
|
Arthritis in color : by
Material type:  Text Text
Publication details: Philadelphia, PA : Saunders/Elsevier, c2009
Availability: Items available for loan: Directorate of Library Services (2)Call number: MED RC933.B785, ...
|
|
|
294.
|

Image from Amazon.com
|
|
|
|
295.
|

Image from Amazon.com
|
Tumours of infancy and childhood by
Material type:  Text Text
Publication details: Oxford Philadelphia Blackwell Scientific Pub. distributed by J. B. Lippincott, 1976
Availability: Items available for loan: Directorate of Library Services (3)Call number: MED RC281.C4T8, ...
|
|
|
296.
|

Image from Amazon.com
|
Color atlas of oral manifestations of AIDS / by
Material type:  Text Text
Publication details: Burlington, Ont. ; Philadelphia, Pa. : B.C. Decker, 1989
Availability: Items available for loan: Directorate of Library Services (1)Call number: MED RC815.S53.
|
|
|
297.
|

Image from Amazon.com
|
|
|
|
298.
|

Image from Amazon.com
|
Medical genetics by
Edition: 4th ed.
Material type:  Text Text
Publication details: Philadelphia : Mosby/Elsevier, 2010
Availability: Items available for loan: Directorate of Library Services (2)Call number: RB155.J67, ...
|
|
|
299.
|
Image from Amazon.com
|
|
|
|
300.
|

Image from Amazon.com
|
Emery's elements of medical genetics. by
Edition: 14th ed. /
Material type:  Text Text
Publication details: Philadelphia, PA : Elsevier/Churchill Livingstone, 2012
Availability: Items available for loan: Directorate of Library Services (3)Call number: MED RB155.E5, ...
|
